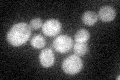
YHR102W
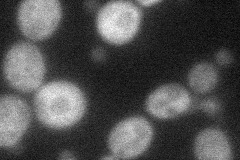
YHR102W
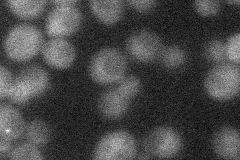
YHR102W
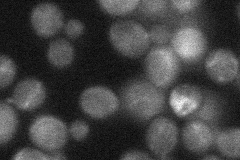
YHR102W
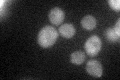
YHR102W
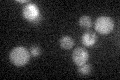
YHR102W

View description
Protein kinase of the PAK/Ste20 kinase family, required for cell integrity possibly through regulating 1,6-beta-glucan levels in the wall; physically interacts with Cdc31p (centrin), which is a component of the spindle pole body
Localization:
Intensity:
Fold change:
Significance:
-
C’ GFP library in SD
cytosol26.11 -
N' NOP1pr-GFP in SD
cytosol35.7667 -
N' TEF2pr-mCherry in SD
cytosol16.5981 -
N' NATIVEpr-GFP in SD
below threshold28.3361 -
N' TEF2pr-VC and Cyto-VN in SD

below threshold29.5349 -
C’ GFP library in SD+DTT
cytosol28.571.09No -
C’ GFP library in SD+H2O2

cytosol30.861.18No -
C’ GFP library in Starvation Media
cytosol23.40.89No -
C’ GFP library on the background of Pup2-DaMP

cytosol -
C’ GFP library on the background of CCT mutant

cytosol21.90350.838892No
